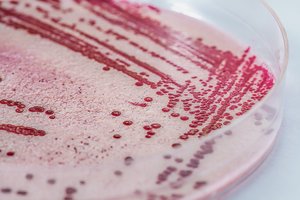
Um Listerien nachzuweisen, werden die Bakterien aus einer Probe kultiviert. Von Auge sehen oder riechen kann man eine Kontamination von Lebensmitteln mit Listerein nicht. (Bild Adobe Stock)

Für Personen mit intaktem Immunsystem verläuft eine Infektion mit Listeria monocytogenes, wie sie bei der Käserei Studer entdeckt worden sind, meist unbemerkt oder nur mit milden Symptomen. Risikogruppen können aber ernsthafte gesundheitliche Probleme bekommen. Man nehme diese Angelegenheit sehr ernst, versichert die Käserei Studer auf ihrer Website.
Kontamination nicht ausgeschlossen
Da man nicht ausschliessen könne, dass neben dem «Füürtüfel» noch andere Käse im Reifekeller mit Listerien kontaminiert worden sind, ruft die Käserei Studer alle ihre gereiften Produkte zurück. Es handelt sich also um eine Sicherheitsmassnahme im Sinne der Vorsorge, denn die Sicherheit der Konsument(innen) habe oberste Priorität. Betroffen sind gemäss Mitteilung 30 verschiedene Produkte.
Produktion läuft weiter
Die Kontamination trat im Reifungskeller der Käserei Studer in Hefenhofen TG auf. Die Käseproduktion findet aber in einem separaten Gebäude statt und laufe weiterhin auf Hochtouren. Die Reifung geschehe extern. Die Lieferfähigkeit könne so nach Ablauf der entsprechenden Reifezeit vollumfänglich wiederhergestellt werden. Eine Teilmenge von «Der scharfe Maxx» werde ausserdem in wenigen Wochen wieder limitiert im Handel verfügbar sein, da diese in einem externen Aussenlager reifen.
Bisher keine Krankheitsfälle
Nach Angaben der Käserei gibt es zum jetzigen Zeitpunkt keine Hinweise auf Erkrankungen oder Todesfälle im Zusammenhang mit diesem Listerienfall.